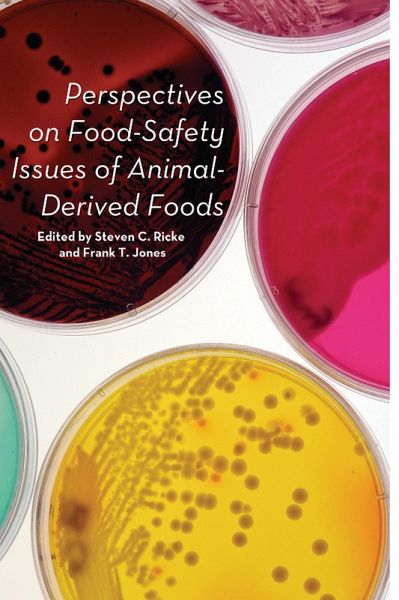
Perspectives on Food-Safety Issues of Animal-Derived Foods (eBook, PDF) Perspectives on Food-Safety Issues of Animal-Derived Foods (eBook, PDF)

Perspectives on Food-Safety Issues of Animal-Derived Foods (eBook, PDF)
Versandkostenfrei!
Sofort per Download lieferbar
51,95 €
inkl. MwSt.
Weitere Ausgaben:
PAYBACK Punkte
26 °P sammeln!
As recent stories in the news have shown, maintaining the integrity of the food supply is of critical importance to the consumer. Thousands of Americans die each year from food-borne illnesses, and millions more get sick. Tremendous strides have been made to reduce the incidence of food-borne diseases originating from animal-derived foods, but food safety and food-borne pathogens continue to remain problematic throughout the world. Food-safety scientists from around the nation continue to conduct groundbreaking research not only to understand causative factors in food-borne pathogen prevalence...
As recent stories in the news have shown, maintaining the integrity of the food supply is of critical importance to the consumer. Thousands of Americans die each year from food-borne illnesses, and millions more get sick. Tremendous strides have been made to reduce the incidence of food-borne diseases originating from animal-derived foods, but food safety and food-borne pathogens continue to remain problematic throughout the world. Food-safety scientists from around the nation continue to conduct groundbreaking research not only to understand causative factors in food-borne pathogen prevalence but to develop novel intervention strategies for limiting contamination in all phases of food animal production. The twenty-four essays in this book highlight research efforts of researchers from the tristate Food Safety Consortium established in 1988 by Congress as a research alliance of food-safety scientists at the University of Arkansas, Iowa State University, and Kansas State University. Members of the consortium conduct research through an annual grant approved by Congress and administered by the U.S. Department of Agriculture. Its mission is to conduct extensive investigation into all areas of poultry, beef, and pork meat production, from the farm to the consumer's table. In addition to the consortium researchers, collaborative university researchers, government officials, and industry personnel provide timely reviews of their latest findings with regard to five significant subject areas: preharvest food-borne pathogen ecology and intervention strategies, postharvest food-borne pathogen ecology, rapid methods and detection strategies for food-borne pathogens, antibiotics and antimicrobials in food safety, and emerging issues in food safety. Progress in these research areas provides opportunities to further enhance protection of animal-derived foods from farm to fork.
Dieser Download kann aus rechtlichen Gründen nur mit Rechnungsadresse in A, B, BG, CY, CZ, D, DK, EW, E, FIN, F, GR, HR, H, IRL, I, LT, L, LR, M, NL, PL, P, R, S, SLO, SK ausgeliefert werden.